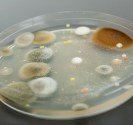

Sommaire
- Résumé sur la maladie de la dermite seborrhéique
- Synonymes de la dermite séborrhéique
- Définition dermite séborrhéique
- Causes de la dermite séborrhéique
- Symptômes de la dermite séborrhéique
- Variétés de dermite séborrhéique
- Dermite séborrhéique du visage et du tronc
- État pelliculaire du cuir chevelu
- Dermite séborrhéique accompagnant d’autres affections
- Diagnostic de la dermite séborrhéique
- Examens utiles
- Maladies similaires à la dermite séborrhéique
- Psoriasis & sébopsoriasis
- Dermatite atopique
- Rosacée et dermatose mixte
- Peut on guérir de la dermite séborrhéique ?
- Impact du dermite séborrhéique sur la qualité de vie
- Existe-t-il des traitements de la dermite séborrhéique ?
- État pelliculaire du cuir chevelu
- Dermite séborrhéique du visage et du tronc
- Dermatite séborrhéique sévère
- Dermite séborrhéique du nourrisson et de l’enfant
- Photographies
- Bibliographie
- Essais cliniques en cours
- Mots à connaître
- NOS AUTRES FICHES SUR LA PEAU
Résumé sur la maladie de la dermite seborrhéique
La dermite séborrhéique est une affection fréquente qui touche plus d’un million de Français (2% de la population). Le sébum favorise la prolifération de champignons du type Malassezia sp dont le rôle est connu dans la genèse de l’affection. Le stress et les facteurs émotionnels ont un rôle aggravant.
Il existe plusieurs formes de cette affection qui peut toucher le visage et le tronc, le cuir chevelu (pellicules) et l’enfant.
La dermite est une affection chronique qui ne guérit pas définitivement, plusieurs traitements sont efficaces pour la faire disparaître et la contrôler.
Synonymes de la dermite séborrhéique
Eczéma séborrhéique, sébopsoriasis, pellicules, pityriasis capitis, pityriasis stéatoide, fausse teigne amiantacée, maladie de Leiner-Moussous.
Définition dermite séborrhéique
La dermite séborrhéique est une affection inflammatoire très fréquente, elle touche entre 2 et 5 % de la population. La dermite provoque des plaques rouges qui pèlent et desquament, elle se localise dans les régions riches en glandes sébacées du visage (autour du nez, entre les yeux), du cuir chevelu ou du thorax. Cette affection est plus fréquente chez l’adolescent, mais se rencontre aussi chez le petit enfant. La dermite séborrhéique touche en général des patients en bonne santé, mais elle est particulièrement fréquente chez ceux qui présentent une maladie de Parkinson, un cancer des voies digestives supérieures, un éthylisme chronique ou le syndrome d’immunodéficience humaine.
Causes de la dermite séborrhéique
Rôle du sébum et de Malassezia sp.
La cause de la dermite séborrhéique n’est pas connue, on incrimine une levure du nom de Malassezia restricta. Ce champignon saprophyte est normalement présent à l’orifice des poils, il prolifère particulièrement dans les régions séborrhéiques – zones où la peau est grasse, riche en sébum et en glandes sébacées. Le système immunitaire est probablement impliqué dans la genèse de cette affection.
Symptômes de la dermite séborrhéique
La dermite séborrhéique provoque des plaques légèrement rouges dont la surface pèle et desquame. L’intensité est variable, souvent majorée par la fatigue, le stress et les facteurs émotionnels.
Variétés de dermite séborrhéique
Dermite séborrhéique du visage et du tronc
La dermatite séborrhéique du visage est la forme la plus évocatrice de l’affection, elle touche plus souvent les hommes après l’adolescence. Les régions autour du nez, entre les yeux et à la lisière du cuir chevelu sont affectées par les plaques rouges et desquamatives plus ou moins affligeantes. La bordure des paupières peut être rouge, inflammatoire et irritée (blépharite). Une atteinte des conduits auditifs et du pli derrière l’oreille peut aussi se voir. Les lésions se développent parfois dans les régions pileuses, chez les hommes qui portent la barbe ou la moustache. Les plaques de dermite s’améliorent au soleil.
La dermite séborrhéique du tronc peut accompagner de celle du visage, elle provoque des plaques rouges et squameuses au milieu du thorax et du dos. Les plis sont parfois affectés (aisselles, aines, sous les seins).
État pelliculaire du cuir chevelu
Les pellicules sont une des formes les plus fréquentes de la dermite. Le pityriasis simplex se traduit par de petites squames à la surface du cuir chevelu qui s’émiettent sur les épaules. Les squames peuvent être plus épaisses et adhérentes, le cuir chevelu est alors rouge et inflammatoire. Les démangeaisons sont fréquentes et soulagées par le shampooing. Les lésions cutanées prédominent souvent à la bordure des cheveux où elles forment une lisière rouge et squameuse.
Les formes sévères peuvent provoquer des croûtes épaisses qui enserrent les cheveux (fausse teigne amiantacée) et forment un casque séborrhéique. Lorsque les squames très grasses recouvrent le cuir chevelu, on parle de pityriasis stéatoide.
Dermite séborrhéique du nouveau-né et du nourrisson. Elle se manifeste par des croûtes jaunâtres du visage et du cuir chevelu (croûtes de lait) chez le petit bébé, celles ci peuvent s’accompagner de plaques croûteuses des fesses et des aisselles. Si les lésions s’étendent, le bébé peut être recouvert d’une éruption rouge et desquamative – c’est l’érythrodermie de Leiner-Moussous. La maladie de Leiner-Moussous régresse en général assez rapidement, mais elle se prolonge parfois par un eczéma atopique ou d’un psoriasis de l’enfant dont elle peut représenter les premiers symptômes.
Dermite séborrhéique accompagnant d’autres affections
La dermite séborrhéique touche en général des patients en bonne santé, mais elle est particulièrement fréquente chez ceux qui présentent une maladie de Parkinson, un cancer des voies digestives supérieures, un éthylisme chronique, ou le syndrome d’immunodéficience humaine.
Diagnostic de la dermite séborrhéique
Une éruption qui forme des plaques rouges et squameuses du visage dans les régions séborrhéiques est caractéristique, surtout si l’éruption se majore lors d’épisodes de stress et s’accompagne d’un état pelliculaire. La dermite séborrhéique est en général un diagnostic facile pour le dermatologue.
Examens utiles
En général, aucun examen complémentaire n’est utile pour affirmer une dermite séborrhéique. Une biopsie de peau est très rarement demandée.
Maladies similaires à la dermite séborrhéique
Psoriasis & sébopsoriasis
La dermite séborrhéique est proche du psoriasis du visage avec laquelle on peut le confondre, ce d’autant que les traitements de la dermite séborrhéique du visage améliorent aussi le sébopsoriasis.
Le dermatologue suspecte un psoriasis quand les lésions sont intenses et persistantes, touchent le conduit auditif et le pli derrière l’oreille, s’accompagnent de lésion de psoriasis des coudes, des genoux, des plis ou d’antécédents familiaux de psoriasis. Au cuir chevelu, le psoriasis donne des plaques plus épaisses et plus rouges avec des squames de couleur argentées.
Dermatite atopique
Les patients adultes peuvent présenter un eczéma atopique persistant au visage, celui ci peut être difficile à distinguer d’une dermite séborrhéique.
Rosacée et dermatose mixte
La dermatose mixte est l’association d’une dermite séborrhéique et d’une rosacée qui pose des problèmes thérapeutiques particuliers.
Peut on guérir de la dermite séborrhéique ?
La dermite séborrhéique ne guérit pas définitivement, mais les traitements sont très efficaces pour la faire disparaître et la contrôler.
Impact du dermite séborrhéique sur la qualité de vie
Certaines formes sévères de dermite séborrhéique peuvent altérer sérieusement la qualité de vie des patients qui en sont affectés.
Existe-t-il des traitements de la dermite séborrhéique ?
Les traitements atténuent et font disparaître temporairement la dermite séborrhéique, mais ne la guérissent pas. Un traitement d’entretien est nécessaire pour éviter une récidive rapide de l’affection après le traitement d’attaque.
État pelliculaire du cuir chevelu
La dermite séborrhéique du cuir chevelu est extrêmement fréquente et ne nécessite souvent pas de traitement médicamenteux.
Shampooing fréquent: les shampooings fréquents améliorent la dermite séborrhéique, ceux-ci peuvent être quotidiens
Shampooings spécifiques : les shampooings antipelliculaires classiques que l’on trouve en supermarché (Head and Schoulder, Klorane…) ou en parapharmacie (Nodé DS+, Nodé K, Squaphane, kélual DS shampooing, kertyol…) sont souvent efficaces, il faut les utiliser un jour sur deux en prenant soin de laisser agir le produit au moins cinq minutes. On peut alterner un shampooing traitant avec un shampooing normal et espacer progressivement les shampooings traitants par la suite.
Il existe de nombreux shampooings spécifiques, il n’est pas possible de tous citer ici – les principes actifs sont : la pyrithione de zinc, le sulfure de sélénium, l’acide salicylique, la piroctone-olamine, le ciclopirox, l’huile de cade, les antifongiques du type climbazole ou clotrimazole.
Shampoings médicamenteux : il semble excessif d’utiliser des shampoings médicamenteux au cours des états pelliculaires usuels, ils sont réservés aux formes sévères de la dermite séborrhéique du cuir chevelu. Il s’agit de shampooings sur prescription à base de kétoconazole (kétoderm gel moussant®), cyclopirox olamine (sébiprox shampooing®) ou de propionate de clobétasol (clobex®). Les shampoings traitants sont utilisés un jour sur deux au début puis une ou deux fois par semaine en entretien. Il faut laisser agir le produit suffisamment longtemps (bien lire la notice) et alterner avec un shampooing antipelliculaire classique.
Lotions traitantes
Elles contiennent des principes actifs similaires aux shampooings et sont utiles si l’on veut éviter de faire un shampooing quotidien. Les lotions du type Kélual DS peuvent être utilisées. En cas de dermite séborrhéique plus importante, le médecin prescrit parfois des lotions à base de corticoides (localone®, diprosalic®) qui agissent plus rapidement – elle sont parfois utiles en application séquentielle (une ou deux fois par semaine), pour entretenir les résultats.
Dermite séborrhéique du visage et du tronc
Il existe de nombreux traitements efficaces de la dermite séborrhéique du visage et du tronc.
La dermite séborrhéique banale peut bénéficier de soins cosmétiques avec des agents antifongiques semblables à ceux utilisés pour celle du cuir chevelu (Kélual DS par ex). Les crèmes à la cortisone faible (Tridésonit®, Locapred®) peuvent être utilisées les premiers jours pour obtenir un effet rapide – il ne faut pas les utiliser au long cours car il y a un risque de dépendance. Les crèmes antifongiques (Kétoderm crème ® au kétoconazole & Amycor® crème au Bifonazole) qui sont efficaces peuvent être utilisées en entretien une ou deux fois par jour. La crème à base de succinate de Lithium à 8% ( Lithioderm®) a fait la preuve de son efficacité dans cette indication.
Les lésions s’estompent en général sous deux semaines, mais reviennent rapidement si l’on ne fait pas le traitement d’entretien indéfini (une à trois fois par semaine) avec une crème antifongique ou au lithium.
Dermatite séborrhéique sévère
Les formes sévères peuvent bénéficier de traitements par voie orale avec la terbinafine ou le fluconazole. Le kétoconazole qui est très efficace, a été délaissé du fait des complications hépatiques parfois sévères. La photothérapie ou l’isotrétinoine sont plus rarement utilisés. Un traitement local est indispensable pour compléter le traitement systémique. La pommade à base de tacrolimus (Protopic®) a montré son efficacité dans les sébopsoriasis du visage.
Dermite séborrhéique du nourrisson et de l’enfant
Le traitement n’est pas indispensable. Les applications locales de kétoconazole ou ciclopiroxolamine topique sont rapidement efficaces.
Photographies
Seborrheic Dermatitis – Dermis
Bibliographie
Dermatoses faciales in dermatologie et infections sexuellement transmissibles. B. Cribier in Dermatologie et Infection Sexuellement Transmissible. JH Saurat, JM Lachapelle, D Lipsker, L Thomas.
Seborrhoeic Dermatitis. British Association of Dermatologists patient information leaflet. Produced august 2004, updated january 2012.
Seborrheic Dermatitis : American Academy of Dermatology
Essais cliniques en cours
Seborrheic dermatitis – Clinicaltrial.org
Mots à connaître
Sébopsoriasis : Psoriasis localisé au visage.
Pityriasis capitis : État pelliculaire du cuir chevelu.
Pityriasis stéatoide : État pelliculaire sévère du cuir chevelu, avec des squames grasses et adhérentes et une odeur désagréable.
Fausse teigne amiantacée : État pelliculaire sévère du cuir chevelu, avec des squames épaisses qui engainent les cheveux.
Maladie de Leiner-Moussous : éruption généralisée du bébé qui se traduit par une rougeur et une desquamation dans le cadre de la dermite séborrhéique. Cette affection sans gravité disparaît en général sans traitement, mais peut laisser place à un eczéma atopique ou un psoriasis.